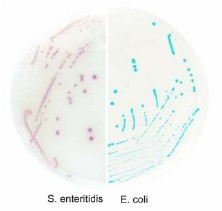

【用途】 用于食品或环境样本中沙门氏菌的筛选和分离。
【规格】 干粉培养基,34.5g/1L/瓶
【配制】
1.称取基础培养基 34.5g 于 1L 蒸馏水或去离子水中(可根据实验实际需要配比加水);充分混匀,
加热并不断搅拌至完全溶解;煮沸灭菌约 2min;
2.灭菌后的培养基冷却至 55℃时,铺平板,待培养基完全凝固后使用。
【pH 值】 7.2(25℃)
【试验步骤】
1.按照各检验标准进行取样及进行沙门氏菌增菌培养;
2.无菌操作,接种环蘸取增菌液划线接种至制备好的平板上,36±1℃倒置培养 24~48h,观察结果;
3.调取可疑沙门氏菌单菌落(圆形、光滑突起的红紫色菌落)进行生化或血清学确证试验。
标准菌株的形态
| 标准菌株 | 菌落形态 |
| 沙门氏菌 | (浅)紫红色 |
| 其他 | 蓝绿色菌落、不显色或抑制 |
【说明】
1. 沙门氏菌在该显色培养基上菌落呈(浅)紫红色,非沙门氏菌在显色培养基上形成蓝绿色菌落、无
色菌落或者生长受到抑制;
2. 假单胞菌属内铜绿假单胞在该培养基制备的平板上呈(浅)
红色,菌落细小,样品经过选择性增菌可以将其部分或完全
抑制。
【保存】
干粉培养基于 30℃以下阴凉干燥处存放,制备好的平板于 2~8
℃避光,可保存 1 周。

手机版




